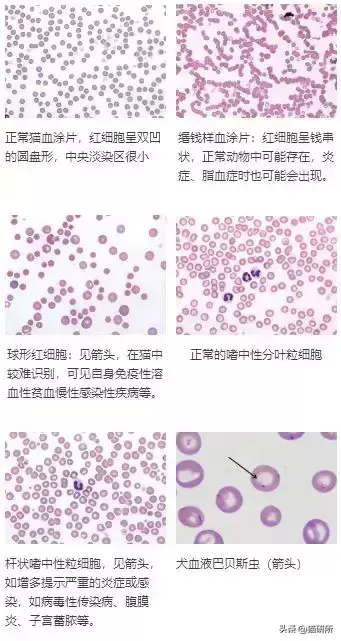
给猫咪做检查血常规查什么？通过血常规一眼就可以看出哪些问题？(图11)

大多数猫咪家长都在宠物医院碰到过上述事项情况,肯定心里也有一些疑问:血常规检查到底是什么检查?什么呢时候不需要做血常规?我家猫猫有还没有必要做?是从血常规更说明都有什么问题? 今天我们就来一聊临床上广泛应用的检查之一血常规。
今天我们就来一聊临床上广泛应用的检查之一血常规。 血常规,临床医学术语是全血细胞计数(completebloodcount,CBC),也可以为了先检测血细胞数量和形态。血常规反映了猫猫当前全身的健康状况,是最基础的血液检查。目前,临床上广泛自动启动血球分析仪参与定量分析先检测(相同仪器可以参考值很可能必然差异);用比较新鲜的血液制备过程血涂片,被染色后在显微镜下参与形态学讲,比较多定量精准指标见下表。
血常规,临床医学术语是全血细胞计数(completebloodcount,CBC),也可以为了先检测血细胞数量和形态。血常规反映了猫猫当前全身的健康状况,是最基础的血液检查。目前,临床上广泛自动启动血球分析仪参与定量分析先检测(相同仪器可以参考值很可能必然差异);用比较新鲜的血液制备过程血涂片,被染色后在显微镜下参与形态学讲,比较多定量精准指标见下表。
 检查血常规是对猫咪体况的另一个基本上评估。个人建议每只出现临床症状的猫咪、麻醉前猫咪和每只老年性猫咪做实验室检查时,都应参与做血常规。
检查血常规是对猫咪体况的另一个基本上评估。个人建议每只出现临床症状的猫咪、麻醉前猫咪和每只老年性猫咪做实验室检查时,都应参与做血常规。 临床上CBC可以不应用于贫血、急性出血、脱水、炎症、感染、免疫抑制等多种肿瘤的诊断。在某些特殊的方法时刻,还可知道一点机体的造血系统功能状态,对评估体况、预后和机体对治疗的反应都有不重要参考价值!
临床上CBC可以不应用于贫血、急性出血、脱水、炎症、感染、免疫抑制等多种肿瘤的诊断。在某些特殊的方法时刻,还可知道一点机体的造血系统功能状态,对评估体况、预后和机体对治疗的反应都有不重要参考价值! CBC阐述红细胞:主要功能是运输氧气和二氧化碳,并对酸碱物质更具pps加速器作用,其主要指标确定诊断意义见下表。
CBC阐述红细胞:主要功能是运输氧气和二氧化碳,并对酸碱物质更具pps加速器作用,其主要指标确定诊断意义见下表。 表1.红细胞去相关指标对确定诊断的总是显示意义注:相对于突然增多:血容量减少(如失水)可能导致的红细胞计数假性升高,非实质性逐渐减少白细胞统称嗜中性粒细胞、嗜碱性粒细胞、嗜酸性粒细胞、单核细胞、单核细胞五种,其主要功能是防御和吞噬病原微生物、参加过敏反应等,诊断意义详见下表。
表1.红细胞去相关指标对确定诊断的总是显示意义注:相对于突然增多:血容量减少(如失水)可能导致的红细胞计数假性升高,非实质性逐渐减少白细胞统称嗜中性粒细胞、嗜碱性粒细胞、嗜酸性粒细胞、单核细胞、单核细胞五种,其主要功能是防御和吞噬病原微生物、参加过敏反应等,诊断意义详见下表。 表2白细胞指标对确诊的提示意义*代表下限为0,临床上并不多能猜得出。核左移:外周血中不长大成熟的嗜中性粒细胞渐增。血小板可辅助止血、促进血管自动愈合、保护血管的完整性,是机体算正常凝血不可或缺的部分的因素,其检查诊断意义见下表。
表2白细胞指标对确诊的提示意义*代表下限为0,临床上并不多能猜得出。核左移:外周血中不长大成熟的嗜中性粒细胞渐增。血小板可辅助止血、促进血管自动愈合、保护血管的完整性,是机体算正常凝血不可或缺的部分的因素,其检查诊断意义见下表。 表3血小板指标对诊断的提示意义
表3血小板指标对诊断的提示意义 (1)观察红细胞的大小、形态有无存在地异常:通过红细胞形态鉴定贫血及贫血类型,评估血液再生情况。(2)核左移:提示病毒性疾病和极为严重的感染。(3)白细胞中毒性变化:总是显示存在地相当严重的炎性疾病和毒血症(如猫瘟、腹膜炎等)。(4)评估所血小板形态、是否是游离:会出现颗粒相对多或只含少量大颗粒的颗粒会减少的血小板显示发育异常,可依据血小板在体外情况校检血小板数量。(5)检查是否需要存在地血液寄生虫。血涂片分析
(1)观察红细胞的大小、形态有无存在地异常:通过红细胞形态鉴定贫血及贫血类型,评估血液再生情况。(2)核左移:提示病毒性疾病和极为严重的感染。(3)白细胞中毒性变化:总是显示存在地相当严重的炎性疾病和毒血症(如猫瘟、腹膜炎等)。(4)评估所血小板形态、是否是游离:会出现颗粒相对多或只含少量大颗粒的颗粒会减少的血小板显示发育异常,可依据血小板在体外情况校检血小板数量。(5)检查是否需要存在地血液寄生虫。血涂片分析 注:图片本文摘自AtlasforCanineand Feline Peripheral Blood猫咪家长们要知道一点儿,没有哪种测试对一种疾病有100%的敏感性和100%特异性!※血常规参考区间(算正常参考值)是由95%的正常了动物试验结果统计不出,只不过有5%的正常吗动物(20个中有两个)其结果是在参考区间其他!※况且,并非所有的“应该要”十分的化验结果在患病时动物中也是极其的,如正常WBC没法首先排除传染病、炎症!也就是说,在参考区间之外的不一定是无比的,而在参考区间内的也不是一定会正常了的!所有的的实验室数据都应该是增强病史、临床症状、身体检查及其余诊断结果进行分析诊断。血常规不是“万能”的!但还没有血常规也是万万不可不能不能的!
注:图片本文摘自AtlasforCanineand Feline Peripheral Blood猫咪家长们要知道一点儿,没有哪种测试对一种疾病有100%的敏感性和100%特异性!※血常规参考区间(算正常参考值)是由95%的正常了动物试验结果统计不出,只不过有5%的正常吗动物(20个中有两个)其结果是在参考区间其他!※况且,并非所有的“应该要”十分的化验结果在患病时动物中也是极其的,如正常WBC没法首先排除传染病、炎症!也就是说,在参考区间之外的不一定是无比的,而在参考区间内的也不是一定会正常了的!所有的的实验室数据都应该是增强病史、临床症状、身体检查及其余诊断结果进行分析诊断。血常规不是“万能”的!但还没有血常规也是万万不可不能不能的!
给猫咪做检查血常规查什么?通过血常规一眼就可以看出哪些问题?
版权声明:本文部分内容素材来自互联网汇编 如有侵权联系删除






